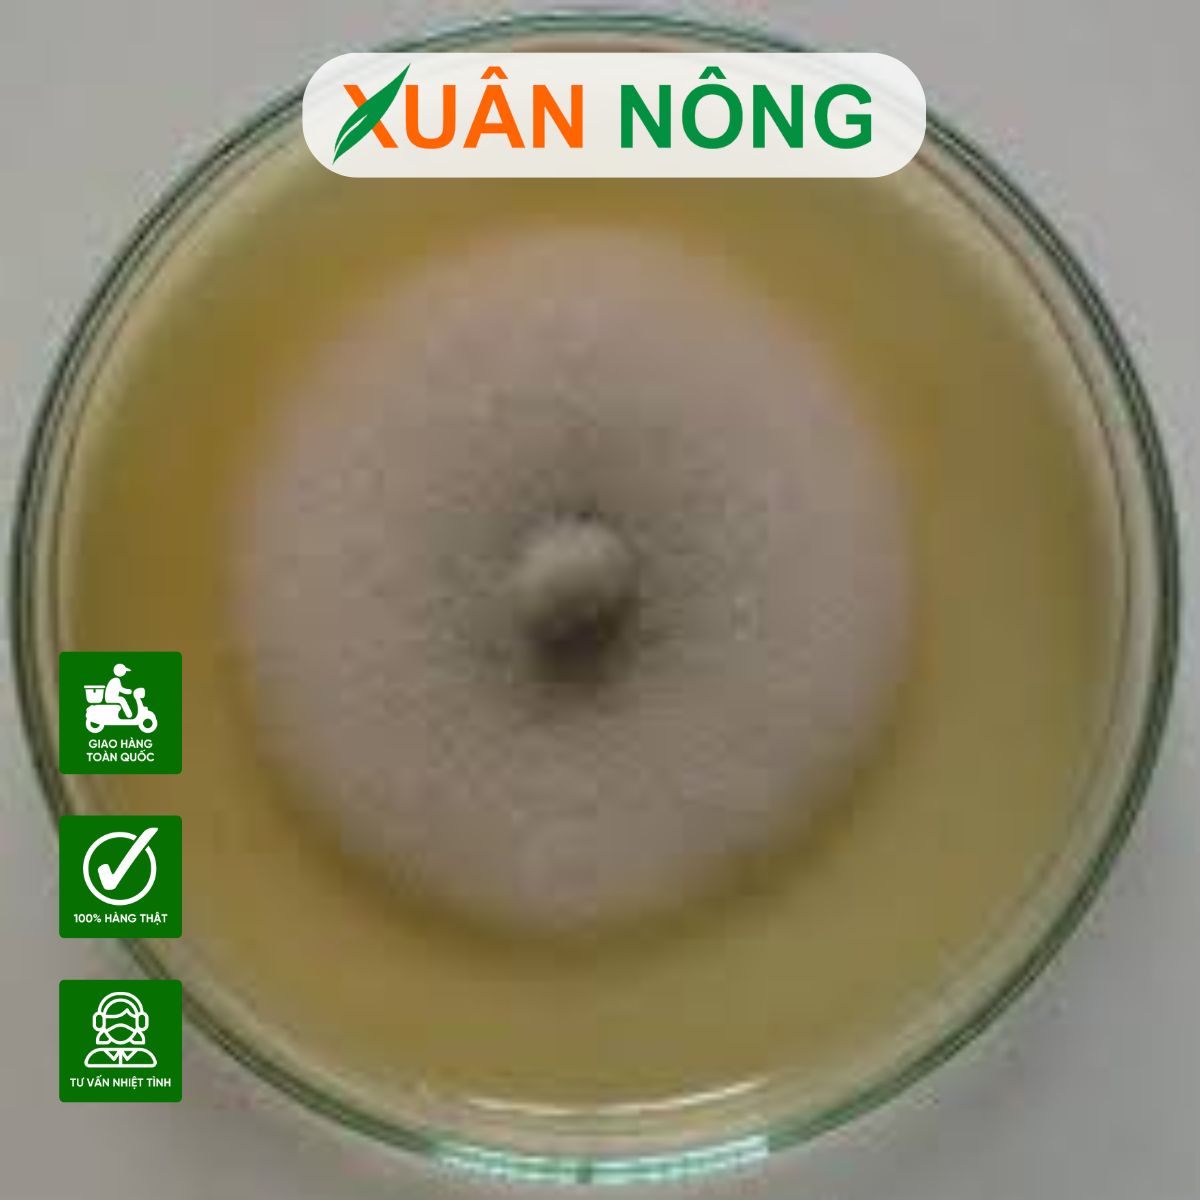

Trong những năm gần đây, xu hướng nuôi cấy nấm Trichoderma tại nhà ngày càng được nhiều bà con nông dân quan tâm. Không chỉ bởi cách làm đơn giản, nguyên liệu dễ tìm, mà còn vì hiệu quả vượt trội trong việc cải tạo đất, phòng ngừa bệnh hại và giảm chi phí mua chế phẩm. Quý bà con hoàn toàn có thể chủ động tự sản xuất nguồn nấm đối kháng ngay tại vườn nhà để sử dụng quanh năm. Nông nghiệp shop sẽ hướng dẫn chi tiết từ A-Z cách làm nấm Trichoderma tại nhà đảm bảo dễ hiểu, dễ làm và cực kỳ hiệu quả.
Tổng quan về nấm Trichoderma và quy trình nuôi cấy
Nấm Trichoderma là gì?
Nấm Trichoderma là nhóm nấm đối kháng hữu ích trong nông nghiệp, có khả năng ức chế và tiêu diệt nấm bệnh như Fusarium, Pythium, Phytophthora… Ngoài ra, Trichoderma còn:
- Giúp tái tạo độ phì nhiêu cho đất.
- Kích thích bộ rễ phát triển mạnh mẽ.
- Tăng cường vi sinh vật có lợi trong đất.
Vì sao nên tự nuôi cấy tại nhà?
- Chủ động nguồn cung: Không lo mua phải hàng kém chất lượng.
- Tiết kiệm chi phí: Tự làm tại nhà rẻ hơn nhiều so với mua sẵn.
- Dễ thực hiện: Nguyên liệu sẵn có, thao tác đơn giản, tỷ lệ thành công cao.
Bà con nào từng thử sẽ thốt lên: “Ôi, dễ hơn mình nghĩ nhiều, lại cực kỳ hiệu quả!”.

Chuẩn bị nguyên liệu và dụng cụ
Nguyên liệu cần có
- Cám gạo: 5kg (có thể thay bằng bột bắp).
- Xơ dừa hoặc mùn cưa: 1kg, đã xử lý nấm mốc.
- Rỉ mật hoặc đường đỏ: 50-100g.
- Nước sạch: 1,5-2 lít.
- Giống nấm Trichoderma: dạng bột hoặc hạt, 1 gói.
Lưu ý: Chọn nguyên liệu sạch, không ẩm mốc, không pha tạp chất để đảm bảo nấm phát triển tốt.
Dụng cụ cần thiết
- Thùng nhựa hoặc khay nhựa có nắp.
- Vải thưa/bao tải sạch để đậy.
- Bình phun sương.
- Nồi hấp hoặc khay hấp (nếu cần khử trùng nguyên liệu).
Quy trình nuôi cấy nấm Trichoderma tại nhà
Khử trùng dụng cụ và nguyên liệu
Rửa sạch thùng, nắp, bình phun. Có thể tráng qua nước sôi hoặc phơi nắng.
Với xơ dừa/mùn cưa: ngâm nước vôi loãng, để ráo trước khi dùng.
Tiến hành cấy giống
- Pha rỉ mật với nước ấm.
- Trộn đều với cám gạo và xơ dừa đến khi độ ẩm đạt 60-70% (nắm chặt hỗn hợp thấy có vài giọt nước rỉ qua kẽ tay là đạt).
- Cho nấm giống vào, trộn thật đều.
- Đổ hỗn hợp vào thùng/bao sạch, không nén chặt. Đậy bằng vải thưa hoặc lá chuối.
Bà con nhớ đừng “quá tay” khi nén, vì nấm cần oxy để phát triển.

Quá trình ủ và phát triển nấm
Điều kiện ủ lý tưởng
- Nhiệt độ: 28-32°C.
- Độ ẩm: 60-70%.
- Nơi ủ: râm mát, thoáng gió, tránh nắng trực tiếp.
- Thời gian ủ: 5-7 ngày.
Kiểm tra sự phát triển
- Sau 2-3 ngày: sợi nấm trắng lan đều.
- Đến ngày 5-6: chuyển sang màu xanh rêu → có thể thu hoạch.
- Nếu xuất hiện màu đen, vàng hoặc mùi hôi → bị nhiễm tạp, cần loại bỏ.
Nhìn nấm xanh rêu phủ đều, bà con sẽ thấy “sướng mắt”, cảm giác thành công ngay!
Thu hoạch và bảo quản
Thời điểm thu hoạch
- Khi sợi nấm phủ xanh đồng đều, chưa khô cứng.
- Thường vào ngày 5-7 sau khi ủ.
Cách bảo quản
- Phơi nắng nhẹ 1-2 ngày hoặc sấy dưới 45°C.
- Bảo quản trong túi PE hoặc hũ kín, nơi khô ráo.
- Sử dụng trong vòng 20-30 ngày.

Ứng dụng của nấm Trichoderma sau khi nuôi cấy
Ủ phân hữu cơ
Phòng bệnh và tuyến trùng
- Hòa nước tưới trực tiếp gốc cây.
- Hoặc rắc quanh rễ để ngăn chặn thối rễ, vàng lá, tuyến trùng.
Nuôi cấy nấm Trichoderma tại nhà không chỉ giúp bà con tiết kiệm chi phí, mà còn mang lại nguồn chế phẩm sinh học sạch, an toàn, phục vụ sản xuất nông nghiệp bền vững. Với quy trình đơn giản, nguyên liệu dễ kiếm và hiệu quả đã được kiểm chứng, bất kỳ hộ nông dân nào cũng có thể áp dụng thành công.

